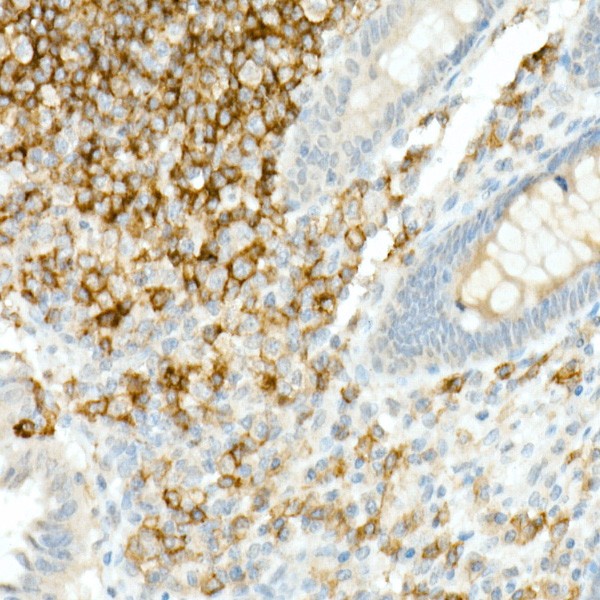
A23507: CD19 Rabbit mAb
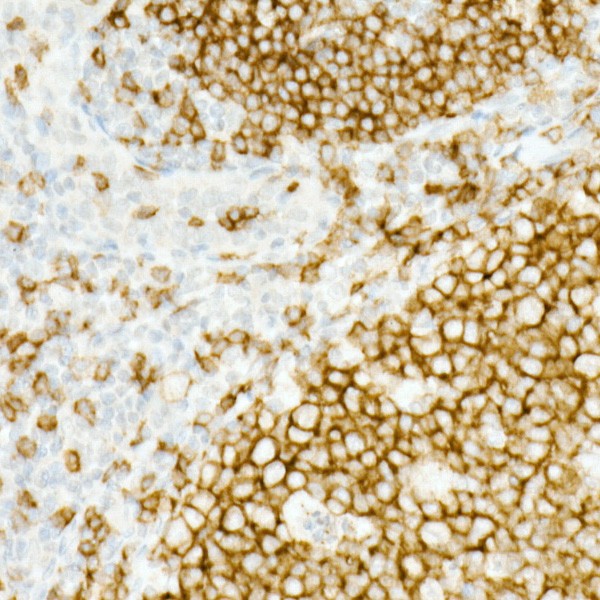
CD19 Rabbit mAb (Catalog Number: A23507) Abclonal

CD19 Rabbit mAb (A23507)
$148.00 – $548.00
Abclonal CD19 Rabbit mAb (Catalog Number: A23507) encodes a member of the immunoglobulin gene superfamily. Expression of this cell surface protein is restricted to B cell lymphocytes.
- Details & Specifications
- References
| Catalog No. | A23507 |
|---|---|
| Product Name | CD19 Rabbit mAb (A23507) |
| Supplier Name | ABclonal, Inc. |
| Brand Name | Abclonal |
| Synonyms | B4; CVID3 |
| Gene Name | CD19 |
| Protein Name | CD19 |
| Uniprot/Swissprot ID | P15391 |
| Gene ID | 930 |
| Clone | ARC51556 |
| Clonality | Monoclonal |
| Source/Host | Rabbit |
| Reactivity | Human |
| Conjugate | Unconjugated |
| Note | Products will be shipped from the warehouse in Massachusetts. Promotion is running from time to time. Welcome to send a request for quote to message@sydlabs.com. |
| Order Offline | Syd Labs, Inc. 4 Avenue E, Hopkinton, MA 01748 USA. Phone: 1-617-401-8149 Fax: 1-617-606-5019 Email: message@sydlabs.com |
Description
A23507: CD19 Rabbit mAb
This gene encodes a member of the immunoglobulin gene superfamily. Expression of this cell surface protein is restricted to B cell lymphocytes. This protein is a reliable marker for pre-B cells but its expression diminishes during terminal B cell differentiation in antibody secreting plasma cells. The protein has two N-terminal extracellular Ig-like domains separated by a non-Ig-like domain, a hydrophobic transmembrane domain, and a large C-terminal cytoplasmic domain. This protein forms a complex with several membrane proteins including complement receptor type 2 (CD21) and tetraspanin (CD81) and this complex reduces the threshold for antigen-initiated B cell activation. Activation of this B-cell antigen receptor complex activates the phosphatidylinositol 3-kinase signalling pathway and the subsequent release of intracellular stores of calcium ions. This protein is a target of chimeric antigen receptor (CAR) T-cells used in the treatment of lymphoblastic leukemia. Mutations in this gene are associated with the disease common variable immunodeficiency 3 (CVID3) which results in a failure of B-cell differentiation and impaired secretion of immunoglobulins. CVID3 is characterized by hypogammaglobulinemia, an inability to mount an antibody response to antigen, and recurrent bacterial infections. Alternative splicing results in multiple transcript variants encoding distinct isoforms.
Immunogen Information about CD19 Rabbit mAb (A23507)
Immunogen:Recombinant protein of human CD19.
Sequence:service@abclonal.com
Gene ID:930
Swiss prot:P15391
Synonyms:B4; CVID3; CD19
Calculated MW:61kDa
Observed MW:95kDa
Images of CD19 Rabbit mAb (A23507)

Western blot analysis of various lysates, using CD19 Rabbit mAb (A23507) at 1:1000 dilution.
Secondary antibody: HRP Goat Anti-Rabbit IgG (H+L) (AS014) at 1:10000 dilution.
Lysates/proteins: 25μg per lane.
Blocking buffer: 3% nonfat dry milk in TBST.
Detection: ECL Basic Kit (RM00020).
Exposure time: 3s.

Immunohistochemistry analysis of CD19 in paraffin-embedded Human appendix using CD19 Rabbit mAb (A23507) at dilution of 1:10000 (40x lens).Perform high pressure antigen retrieval with 10 mM Tris/EDTA buffer pH 9.0 before commencing with IHC staining protocol.

Immunohistochemistry analysis of CD19 in paraffin-embedded Human tonsil using CD19 Rabbit mAb (A23507) at dilution of 1:10000 (40x lens).Perform high pressure antigen retrieval with 10 mM Tris/EDTA buffer pH 9.0 before commencing with IHC staining protocol.

Confocal imaging of paraffin-embedded Human tonsil tissue using CD19 Rabbit mAb (A23507, dilution 1:200) followed by a further incubation with Cy3 Goat Anti-Rabbit IgG (H+L) (AS007, dilution 1:500) (Red). DAPI was used for nuclear staining (Blue). Objective: 40x. Perform high pressure antigen retrieval with 0.01 M citrate buffer (pH 6.0) prior to IF staining.
Please remember our product information: CD19 Rabbit mAb (Catalog Number: A23507) Abclonal